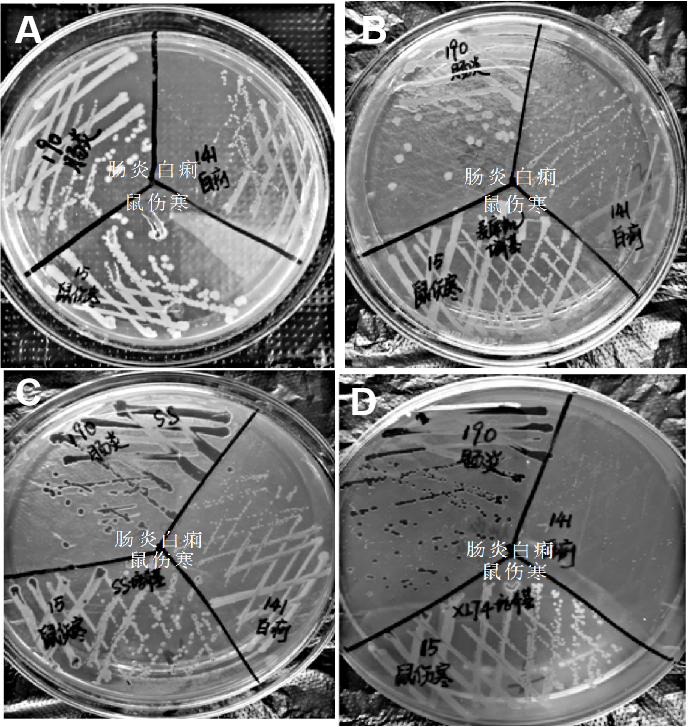
图片1

1.肠炎沙门菌(Salmonella Enteritidis)
物种名:肠炎沙门菌
拉丁学名:Salmonella Enteritidis
分类学地位:细菌界Bacteria;变形菌门Proteobacteria ;
γ-变形菌纲Gammaproteobacteria;肠杆菌目Enterobacterales;
肠杆菌科Enterobacteriaceae;沙门菌属Salmonella
肠炎沙门菌(S. Enteritidis)广泛分布于自然界中,常见于家禽、蛋类、肉类及动物肠道中,可通过污染的食物或水源传播,引发人畜共患感染。近年来,肠炎沙门菌已成为全球食源性疾病的主要病原体之一,由该菌引起的食物中毒事件频发,其发病率在细菌性食物中毒中位居前列,对公共卫生安全构成严重威胁。
1.1生物学特性
1.1.1培养特征
肠炎沙门菌(Salmonella Enteritidis)在普通培养基(如营养琼脂)上形成圆形、光滑、湿润的半透明菌落,在血琼脂上呈灰白色且不溶血。在选择性培养基上,麦康凯琼脂上为无色菌落(不发酵乳糖),SS琼脂和XLD琼脂上因产H₂S可能出现黑色中心,HE琼脂上呈蓝绿色或蓝色。其生化特性表现为TSI斜面碱性/底层酸性且产H₂S,吲哚阴性,MR阳性,VP阴性,能利用柠檬酸盐,尿素酶阴性,具运动性。该菌最适生长温度为37℃,pH 6.5-7.5,耐胆盐[1]。
图1 肠炎沙门菌在各种平板上的培养结果
A:普通营养琼脂,B:麦康凯琼脂
C:SS琼脂,D:XLT4琼脂
1.1.2形态学特征
c
沙门肠炎菌(Salmonella Enteritidis)是一种革兰氏阴性杆菌,形态学特征表现为短杆状,大小约为0.7-1.5 μm × 2.0-5.0 μm,无芽孢、无荚膜,多数菌株具有周生鞭毛,运动活泼[2]。电镜下可见其表面有细密的菌毛。该菌在普通琼脂培养基上形成圆形、光滑、湿润、半透明的灰白色菌落,部分菌株在SS琼脂等选择性培养基上因不发酵乳糖而呈现无色透明菌落[3]。

图2 肠炎沙门菌显微照片
1.1.3生化特征
肠炎沙门菌具有糖代谢的能力,能发酵葡萄糖、麦芽糖、甘露醇产酸产气,但是不发酵乳糖、蔗糖;其酶活性检测显示氧化酶阴性、过氧化氢酶阳性、赖氨酸脱羧酶阳性,且能在三糖铁(TSI)培养基中产生H₂S,导致斜面呈黑色。在耐药性方面,该菌通常对氨苄西林和氯霉素等抗生素敏感,但近年来对氟喹诺酮类等抗生素的多重耐药菌株呈上升趋势。
1.1.4分子生物学特征
肠炎沙门菌基因组大小约4.8 Mbp,包含保守的毒力岛(如SPI-1和SPI-2)及移动遗传元件(质粒、噬菌体)。毒力基因包括invA(侵袭蛋白)、sopE(Ⅲ型分泌系统效应蛋白)和fljB(鞭毛合成基因)[4]。
1.2分布、传播与致病性
1.2.1分布与传播
肠炎沙门氏菌在自然界中分布广泛,其宿主主要包括人类和多种动物(如家禽、家畜及爬行动物),这些动物的消化道常成为病菌的储存库。该菌在环境中生存力较强,可在土壤、水体中存活数周,在粪便中能存活1-2个月,而在牛乳、肉类等食品中甚至可存活数月,成为潜在的传染源[5]。
该菌主要通过三种途径传播:一是食物传播,未煮熟的肉类、蛋类及受污染的乳制品、蔬果是主要载体,食品加工过程中的卫生疏漏会加剧污染风险;二是水源传播,粪便污染的水体或供水系统可引发群体性感染;三是接触传播,包括直接接触感染者排泄物、污染的日常用品或带菌动物,医疗机构和幼托场所的器械、护理人员手部也可能成为传播媒介。这些传播方式凸显了食品安全管理和个人卫生防护的重要性[5]。
1.2.2致病性
肠炎沙门菌是一种常见的食源性致病菌,具有较强的致病性,主要通过消化道传染致病,其致病因素主要有侵袭力、内毒素和肠毒素。
感染后通常在摄入受污染食物后的数小时至数天内出现症状,包括发热、呕吐、腹痛、腹泻等。粪便性状多变,早期多为稀水样或黄绿色黏液便,继而可能出现脓血便或血水样便,伴有腥臭味。严重感染可能导致脱水、电解质紊乱、酸中毒,甚至多脏器功能受累;部分患者可能出现菌血症或败血症,尤其是儿童、老年人和免疫力低下者。菌血症可导致发热、寒战、出汗等症状,严重时可能引发局部化脓性感染,如支气管肺炎、胸膜炎、心内膜炎、脑膜炎;在老人和儿童中,肠炎沙门菌可能引起慢性肠炎,症状相对较轻,但病程较长,可能反复出现腹泻、腹痛等症状[6]。
1.3检测方法
肠炎沙门菌的传统检测方法主要包括分离培养、生化鉴定和血清学鉴定。
(1)分离培养:根据疾病类型采集相应标本(如血液、粪便或食物),接种于SS琼脂、XLD琼脂等选择性培养基,35℃培养18-24小时后观察菌落特征(如XLD平板上中央呈黑色的菌落)。对可疑菌落进行生化鉴定(氧化酶阴性、KIA反应K/A且H₂S强阳性等),最后通过沙门菌多价诊断血清进行玻片凝集试验和抗原分型[7]。
(2)血清学检测方法主要包括肥达试验和ELISA检测。肥达试验通过检测患者血清中伤寒/副伤寒沙门菌O、H抗体的效价变化(第二次效价4倍以上增高有诊断意义)来判断感染情况;ELISA则利用酶标抗体与抗原的特异性结合,通过显色反应判断是否存在肠炎沙门菌抗体,为感染诊断提供依据[7]。
(3)分子生物学检测技术:PCR技术(PCR-CRISPR/Cas12a)通过扩增保守基因实现早期诊断;LAMP技术在等温条件下即可完成核酸扩增,适合现场检测;全基因组测序(WGS)能获取菌株完整基因组信息,用于分型溯源和耐药基因分析,为疫情监控和精准防控提供支持[7]。
1.4典型案例
2020年5月24日12时56分,天津市蓟州区疾病预防控制中心检验科接到区人民医院报告,有4名腹泻患者该区某农家院就餐出现腹泻、腹痛、发热等临床相似症状。4名患者主要以腹泻、发热、腹痛为主,100.0%患者有腹泻,均为水样便,75.0%患者有发热,体温为38.8~39.3℃,75.0%患者有腹痛,为脐周和上腹绞痛,部分患者有恶心、呕吐等症状。1份患者粪便、2份留样食品(腱子肉、香肠)及熟食储存冰箱内壁涂抹物、熟食菜板涂抹物、熟食菜刀涂抹物、熟食菜墩涂抹物中检出肠炎沙门菌,检出率为53.8%。根据流行病学特征、现场卫生学调查、患者临床表现和实验室检测结果,判定本次事件为一起因患者食用了污染肠炎沙门菌的腱子肉和香肠引起的食物中毒[8]。
1.5防治对策
肠炎沙门菌的防治对策主要包括预防措施和治疗方法两大方面。在预防上,应注重个人卫生,如饭前便后彻底洗手;加强食品安全管理,确保肉类、蛋类完全煮熟,避免生熟交叉污染;保持环境清洁,定期消毒厨房用品;同时通过均衡饮食和适度运动增强免疫力。治疗方面,轻症患者以补液和调整饮食为主,重症需根据药敏试验选用抗生素(如头孢菌素),并辅以退热、止泻等对症治疗。患者应隔离至症状消失且粪便培养阴性,家庭成员需做好防护。若出现高热、血便等严重症状,应及时就医。总体而言,预防为主,日常严格做好饮食卫生和个人卫生是关键防控手段[9]。
参考文献
[1] 李玉燕, 巩新民, 祝永华 等. 鸡白痢、鼠伤寒和肠炎沙门氏菌在不同鉴别培养基上的形态. 家禽科学, 2019: 42-44.
[2] 李文均, 陈瑛, 田新朋 等. 《伯杰氏鉴定细菌学手册》和“伯杰氏国际系统微生物学学会”历史回顾、发展现状及未来展望 .微生物学报, 2023.
[3] 周庭银, 赵虎.《临床微生物学诊断与图解》. 上海科学技术出版社, 2017.
[4] 唐正露, 曹堃, 张丽 等. 肠炎沙门氏菌ssrAB、hilA、hilD基因缺失菌株的构建及其生物学特性. 微生物学通报, 2021, 48, :1195-1205.
[5] Chen J, Huang L, An H et al. One Health approach probes zoonotic non-typhoidal Salmonella infections in China: A systematic review and meta-analysis. J Glob Health, 2024, 14: 04256.
[6] 王路才, 撒朗文朱, 张焕容. 禽源肠炎沙门菌的分离鉴定及耐药性与致病性分析. 中国畜牧兽医, 2023, 50: 1663-1674.
[7] 杨天沐, 王毅恒, 熊文广 等. 基于PCR-CRISPR/Cas12a技术的肠炎沙门菌快速检测方法. 华南农业大学学报, 2025, 46: 311-318.
[8] 黄正良, 柳金涛, 胡颖敏 等. 一起肠炎沙门氏菌引起的学生聚集性胃肠炎事件的流行病学调查. 中国初级卫生保健, 2024, 38: 79-81.
[9] 王玲莉, 郑伟, 杨旭辉 等. 杭州市食源性沙门菌病流行病学特征分析. 中国预防医学杂志, 2025, 26: 728-734.
.png)
